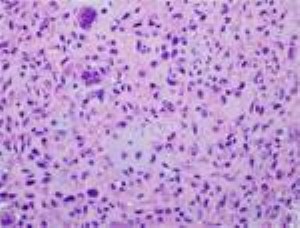

Diseases & Conditions
Chondromyxoid Fibroma
Chondromyxoid fibroma (CMF) is one of the rarest bone tumors, accounting for less than 1% of all bone tumors.
It is a benign (noncancerous) tumor that most often develops in people between the ages of 10 and 30 years. It is slightly more common in males than females.
Treatment for CMF requires surgery to remove the tumor.
Description
Chondromyxoid fibroma grows out of cells found in the marrow of bones that start to make cartilage ("chondro" means cartilage). It typically develops inside the flared end of a long bone in the lower body, such as the tibia (shinbone) or femur (thighbone).
The most common location of CMF is in the tibia near the knee. Other locations include the femur near the knee, the bones of the hand and foot, the spine, and the pelvis (hip area).
CMF does not metastasize (spread to other parts of the body).
Cause of Chondromyxoid Fibroma
The cause of CMF is not known.
There has been no proven connection between the development of CMF and exposure to chemicals, radiation, or any specific activities.
Genetic changes have been identified in CMF, but an underlying genetic cause of the tumor has not been found.
Symptoms of Chondromyxoid Fibroma
- People with chondromyxoid fibroma may be able to feel a bump at the location of the tumor.
- There may be mild to severe pain associated with the bump, or there may be no pain at all.
- In some cases, there is no bump, just a varied amount of pain or swelling in the area of the tumor.
Diagnosing Chondromyxoid Fibroma
Medical History and Physical Examination
There are many aspects to the doctor's examination.
- Before a physical examination, your doctor will talk to you about your general health, as well as your symptoms, to get a good history of the problem. Pain at night or at rest, or pain that just does not go away is more typical of tumors in general, and CMF in particular. In contrast, pain from an injury usually decreases when the injured area is not moving.
- During the physical examination, your doctor will look for tenderness over the bone and check your range of motion in the joint closest to the area of your pain.
Tests
To diagnose CMF, your doctor will order imaging and tissue tests.
X-rays. X-rays provide clear pictures of bone and are very helpful in diagnosing CMF. Most chondromyxoid fibromas are small (1 to 4 cm), round- or oval-shaped tumors. In X-rays, they are often surrounded by a white (sclerotic) rim of bone.
In many cases, the tumor will destroy portions of the bone and aggressively grow, pushing into the surrounding soft tissues. This is why some patients can feel a bump through the skin.
Other imaging tests. While there are usual features of CMF seen on X-rays, many other tumors can have a similar appearance. That is why doctors usually also request computed tomography (CT) scans or magnetic resonance imaging (MRI) scans to help confirm the diagnosis and get a better idea of how much bone is affected by the tumor.
CT and MRI scans provide a lot of detail, especially of the soft tissues. They can also provide cross-sectional images (see image below, on the right) that allow your doctor to look at your tumor as though they sliced through it (along with the affected bone and muscle).
Biopsy. A biopsy is necessary to confirm the diagnosis of CMF. In a biopsy, a tissue sample of the tumor is taken and examined under a microscope. Your doctor may give you a local anesthetic to numb the area and take a sample using a needle. Biopsies can also be performed as an operation.
Under a microscope, chondromyxoid fibromas have elements of normal cartilage (chondroid), plus myxoid and fibrous tissue (leading to the name of the tumor). Myxoid tissue is jelly-like, while fibrous tissue is denser.
Differential Diagnosis
The imaging and tissue tests help your doctor tell CMF apart from other tumors that have a similar appearance, such as giant cell tumor, periosteal chondroma, nonossifying fibroma, chondroblastoma, or infection of the bone (osteomyelitis).
When planning your treatment, it is very important for your doctor to determine whether you have CMF or a more aggressive cancerous tumor like chondrosarcoma or osteosarcoma. This is especially true for CMF tumors that are getting bigger or are already affecting a lot of bone or surrounding muscle.
Treatment for Chondromyxoid Fibroma
Treatment for chondromyxoid fibromas requires surgery. Because CMF is so rare, there are not studies with a lot of patients that can help doctors make recommendations about which type of surgery is best.
Curettage
The most common method of treating CMF is with curettage. In this procedure, the tumor is scraped out of the bone.
After curettage, your doctor may fill the hole with a bone graft — bone taken from a donor (allograft) or from another bone in your body (autograft).
Sometimes, the doctor will place chemicals inside the bone cavity or use a burr to remove as much of the tumor as possible and try to reduce the risk of the tumor growing back.
The bone may also be filled with bone cement that may help reduce the risk of the tumor growing back and can help make the bone hole stronger
Resection
The area of bone involved with CMF may also be removed. This is much more extensive surgery than curettage and is typically used only for large tumors that involve a significant amount of bone.
Surgical Complications
Recurrence (return) of the tumor is the most serious complication of treatment. Even when these tumors are adequately treated, they grow back in the same location up to 25% of the time.
More aggressive surgery — such as removing larger portions of the bone (e.g., resection) — will lessen the chance of the tumor coming back but may have a higher chance of causing surgical complications.
Other complications include infection and, rarely, fracture of the bone through the treated area.
The risk of CMF becoming malignant (cancerous) is extremely small (less than 1%).
Recovery
How long it takes to return to all your daily activities depends on:
- Where the tumor was located
- How large the tumor was
- Which type of surgery you had (curettage or resection)
If you have any pain or discomfort, you may want to limit some activities. Your doctor will provide you with specific instructions to guide your recovery.
Your doctor will monitor you and take routine X-rays for a few years after your surgery to check for tumor recurrence (return). If the tumor comes back, it can be treated using the same methods that were used to treat the original tumor. Your doctor will talk to you about all the options.
Contributed and/or Updated by
Peer-Reviewed by
AAOS does not endorse any treatments, procedures, products, or physicians referenced herein. This information is provided as an educational service and is not intended to serve as medical advice. Anyone seeking specific orthopaedic advice or assistance should consult his or her orthopaedic surgeon, or locate one in your area through the AAOS Find an Orthopaedist program on this website.